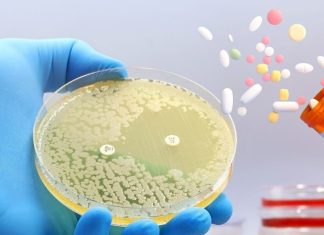
कुछ एंटीबायोटिक दवाएं लिवर को ज्यादा नुकसान क्यों पहुंचाती हैं? आईआईटी बॉम्बे की स्टडी में बड़ा खुलासा

Last Updated:
Mulank 1 Numerology Prediction 2026: साल 2026 को आने में अब बस कुछ ही दिन बचें है, ऐसे में हर कोई जानना चाहता है कि नया साल 2026 कैसा रहने वाला है. ऐसे में आज हम आपको मूलांक 1 वालों के बारे में बताने जा रहे हैं. मूलांक 1 वालों का सामाजिक जीवन, नौकरी व कारोबार समेत जीवन के सभी क्षेत्रों का हाल कैसा रहने वाला है, आइए जानते हैं…

Mulank 1 Varshik Ank Jyotish: साल 2025 को खत्म होने में अब बस कुछ ही दिन बचे हैं और कुछ ही दिनों में नए साल 2026 की शुरुआत होने वाली है. ऐसे में हर कोई जानना चाहता है कि आने वाला साल उसके लिए क्या कुछ खास लेकर आने वाला है और किन चीजों से उन्हें बचने की जरूरत है. अंक शास्त्र से आप इन सवालों के जवाब प्राप्त कर सकते हैं. अंक ज्योतिष एक प्राचीन विद्या है, जो जन्मतिथि के आधार पर सामने वाले व्यक्ति के जीवन के रहस्यों, व्यक्तित्व और भविष्य को समझने का प्रयास करती है. अंक ज्योतिष में आज हम बात करने जा रहे हैं मूलांक 1 वालों की. आइए जानते हैं नया साल 2026 मूलांक 1 वालों के लिए कैसा रहने वाला है…

जिन लोगों का जन्म किसी भी महीने की 1, 10, 19, या 28 तारीख को होता है, उनका मूलांक 1 होता है. मूलांक 1 के स्वामी ग्रहों के राजा सूर्य हैं इसलिए मूलांक 1 वालों पर सूर्य ग्रह का ज्यादा प्रभाव देखने को मिलता है. अंक शास्त्र के अनुसार, मूलांक 1 वालों के लिए आने वाला साल बहुत ही खास और गतिशील साबित होने वाला है. यह साल आपके लिए नेतृत्व, पहल और खुद को साबित करने का सुनहरा मौका लेकर आएगा.

नया साल 2026 मूलांक 1 वालों का आत्मविश्वास और साहस नई दिशा में कदम बढ़ाने में मदद करेगा. आपके व्यक्तित्व और क्षमताओं की वजह से लोग आपकी अलग पहचान बनाएंगे. ध्यान रहे, अहंकार, जल्दबाजी या अधीरता से बचना बहुत जरूरी है. केवल धैर्य और संयम के साथ उठाए गए कदम ही आपको असली सफलता दिलाएंगे.
Add Bharat.one as
Preferred Source on Google

मूलांक 1 वालों के लिए करियर और आर्थिक दृष्टि से साल 2026 बहुत ही फायदेमंद रहेगा. नौकरीपेशा लोगों को पदोन्नति, नई जिम्मेदारी या नेतृत्व का अवसर मिल सकता है. यह समय आपकी मेहनत और काबिलियत को पहचान दिलाने वाला है. वहीं अगर आप बिजनेस या किसी व्यापार से जुड़े हैं, तो नए निवेश और साझेदारी के अवसर आपके लिए लाभकारी साबित होंगे, हालांकि जल्दबाजी या शॉर्टकट लेने से बचें, नहीं तो नुकसान भी हो सकता है. आर्थिक रूप से वर्ष स्थिर रहेगा, लेकिन समझदारी से खर्च और निवेश करना आपके लिए जरूरी होगा.

प्यार और रिश्तों के मामले में 2026 साल बहुत ही सक्रिय रहेगा. विवाहित जातकों को अपने अहंकार और जिद को नियंत्रण में रखना होगा, ताकि जीवनसाथी के साथ अनावश्यक तनाव या विवाद न उत्पन्न हों. निर्णय साझा करना और समझदारी से बातचीत करना रिश्तों में सामंजस्य बनाए रखेगा. अविवाहित जातकों के लिए यह साल नए रोमांटिक अवसर लेकर आएगा. आपका आत्मविश्वास और आकर्षक व्यक्तित्व किसी संभावित साथी का ध्यान अपनी ओर खींच सकता है, लेकिन साथी के चुनाव में समझदारी और स्थायित्व पर ध्यान देना जरूरी होगा ताकि रिश्ता लंबे समय तक मजबूत और संतुलित बना रहे.

स्वास्थ्य की दृष्टि से नया साल 2026 मूलांक 1 वालों के लिए सामान्य रूप से संतुलित रहेगा. आपकी शारीरिक और मानसिक ऊर्जा अच्छी रहेगी, जिससे आप दिनचर्या और जिम्मेदारियों को आराम से निभा पाएंगे. फिर भी लगातार काम या अधिक जिम्मेदारी लेने से थकान और तनाव हो सकता है, इसलिए पर्याप्त नींद और संतुलित भोजन जरूरी है.

सामाजिक जीवन में नया साल 2026 मूलांक 1 वालों के लिए बहुत अवसर लेकर आएगा. आपकी नेतृत्व क्षमता और अनुभव की वजह से लोग आपकी राय को महत्व देंगे. नए मित्र बनाने और सामाजिक नेटवर्क को मजबूत करने के लिए यह समय अनुकूल रहेगा.